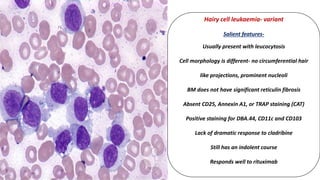
Hairy cell leukaemia- variant
Salient features-
Usually present with leucocytosis
Cell morphology is different- no circumferential hair
like projections, prominent nucleoli
BM does not have significant reticulin fibrosis
Absent CD25, Annexin A1, or TRAP staining (CAT)
Positive staining for DBA.44, CD11c and CD103
Lack of dramatic response to cladribine
Still has an indolent course
Responds well to rituximab
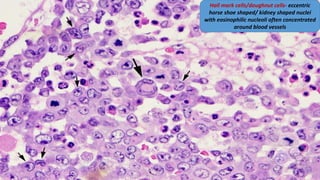
Hall mark cells/doughnut cells- eccentric
horse shoe shaped/ kidney shaped nuclei
with eosinophilic nucleoli often concentrated
around blood vessels

The 2016 revision of the WHO classification of lymphoid neoplasms made several important changes compared to the previous 2008 classification. For chronic lymphocytic leukemia/small lymphocytic lymphoma, it clarified the concept of monoclonal B-cell lymphocytosis as a precursor lesion. For follicular lymphoma, it introduced the terminology of pediatric-type follicular lymphoma and duodenal-type follicular lymphoma. For mantle cell lymphoma, it described the role of SOX11 overexpression and identified CCND2 translocations in cyclin D1-negative cases. It also provided updates for other lymphomas such as diffuse large B-cell lymphoma.